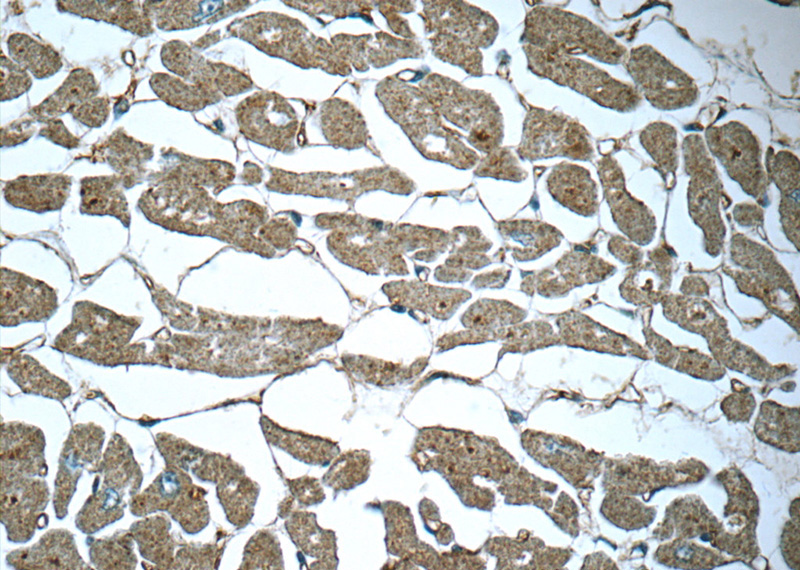

-
Product Name
SIRT2-Specific antibody
- Documents
-
Description
SIRT2-Specific Rabbit Polyclonal antibody. Positive IHC detected in human heart tissue, human skeletal muscle tissue. Positive IF detected in mouse cortex. Positive IP detected in mouse brain tissue. Positive WB detected in rat brain tissue, human brain tissue, mouse brain tissue. Observed molecular weight by Western-blot: 39-47 kDa
-
Tested applications
ELISA, IHC, WB, IF, IP
-
Species reactivity
Human, Mouse, Rat; other species not tested.
-
Alternative names
SIR2 antibody; SIR2 like protein 2 antibody; SIR2L antibody; SIR2L2 antibody; SIRT2 antibody
-
Isotype
Rabbit IgG
-
Preparation
This antibody was obtained by immunization of SIRT2-Specific recombinant protein (Accession Number: XM_006723111). Purification method: Antigen affinity purified.
-
Clonality
Polyclonal
-
Formulation
PBS with 0.1% sodium azide and 50% glycerol pH 7.3.
-
Storage instructions
Store at -20℃. DO NOT ALIQUOT
-
Applications
Recommended Dilution:
WB: 1:200-1:2000
IP: 1:200-1:2000
IHC: 1:20-1:200
IF: 1:50-1:1000
-
Validations

rat brain tissue were subjected to SDS PAGE followed by western blot with Catalog No:115243(SIRT2 antibody) at dilution of 1:600

ICH results of SIRT2 (Catalog No:115243) antibody with cortex slides of SITR2-WT and SIRT2-KO samples.

IP Result of anti-SIRT2 (IP:Catalog No:115243, 4ug; Detection:Catalog No:115243 1:800) with mouse brain tissue lysate 2640ug.
Immunohistochemistry of paraffin-embedded human heart tissue slide using Catalog No:115243(SIRT2 Antibody) at dilution of 1:50
-
Background
The Silent Information Regulator (SIR2) family of genes is a highly conserved group of genes that encode nicotinamide adenine dinucleotide (NAD)-dependent protein deacetylases, also known as Class III histone deacetylases. The first discovered and best characterized of these genes is Saccharomyces cerevisiae SIR2, which is involved in silencing of mating type loci, telomere maintenance, DNA damage response, and cell aging (10545947). SirT2, a mammalian homolog of Sir2, deacetylates α-tubulin at Lys40 and histone H4 at Lys16 and has been implicated in cytoskeletal regulation and progression through mitosis (12620231,16648462). SirT2 protein is mainly cytoplasmic and is associated with microtubules and HDAC6, another tubulin deacetylase (12620231). Deacetylation of α-tubulin decreases its stability and may be required for proper regulation of cell shape, intracellular transport, cell motility, and cell division (12620231,10966460). The abundance and phosphorylation state of SirT2 increase at the G2/M transition of the cell cycle, and SirT2 relocalizes to chromatin during mitosis when histone H4 Lys16 acetylation levels decrease (16648462,12697818). Overexpression of SirT2 prolongs mitosis, while overexpression of the CDC14B phosphatase results in both decreased phosphorylation and abundance of SirT2, allowing for proper mitotic exit (12697818). Thus, the deacetylation of both histone H4 and α-tubulin by SirT2 may be critical for proper chromatin and cytoskeletal dynamics required for completion of mitosis. This antibody recognizes the 37-45 KD SIRT2 proteins. This antibody is a specific antiboy that it can't detect signal with SIRT2-KO samples.
Related Products / Services
Please note: All products are "FOR RESEARCH USE ONLY AND ARE NOT INTENDED FOR DIAGNOSTIC OR THERAPEUTIC USE"
